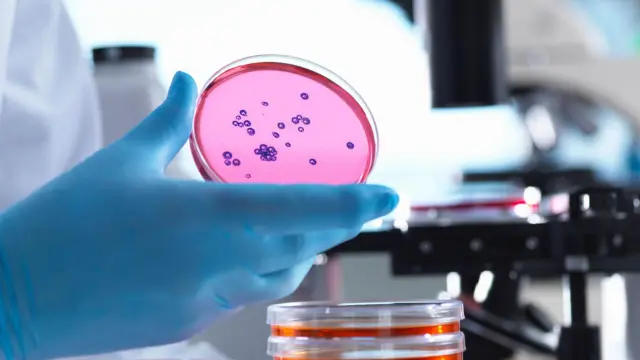
Hand in a blue glove holding a petri dish with small purple growth of bacteria on it

'ยาที่ทำมาจากอึ' คืออะไร ช่วยกำจัดเชื้อดื้อยาในร่างกายได้อย่างไร

ที่มาของภาพ, GSTT
- Author, เจมส์ กัลลาเกอร์
- Role, ผู้สื่อข่าวสุขภาพและวิทยาศาสตร์
แพทย์ชาวอังกฤษกำลังพยายามหาวิธีการกำจัดการติดเชื้อแบคทีเรียดื้อยาที่เป็นอันตราย ด้วยการใช้ "ยาอึ" ที่ประกอบไปด้วยอุจจาระซึ่งผ่านกระบวนการฟรีซ-ดราย (freeze-dried) หรือ การทำแห้งแบบแช่เยือกแข็ง
โดยตัวอย่างอุจจาระที่ใช้มาจากผู้บริจาคที่มีสุขภาพดี และเต็มไปด้วยแบคทีเรียดี
ข้อมูลเบื้องต้นชี้ให้เห็นว่า เชื้อแบคทีเรียดื้อยาสามารถถูกกำจัดออกทางลำไส้ และแทนที่ด้วยแบคทีเรียหลายชนิดที่ดีต่อสุขภาพได้
นี่คือแนวทางใหม่ในการจัดการกับการติดเชื้อดื้อยา ที่เชื่อว่า คร่าชีวิตผู้คนไปราวหนึ่งล้านคนในแต่ละปี
การศึกษามุ่งเป้าไปที่ลำไส้ ซึ่งเป็น "แหล่งกักเก็บเชื้อดื้อยาปฏิชีวนะที่ใหญ่ที่สุดในร่างกายมนุษย์" ดร.แบลร์ เมอร์ริค ซึ่งเป็นผู้กำลังทดลองยาชนิดนี้ในโรงพยาบาลกายส์แอนด์เซนต์โทมัส ระบุ
เชื้อแบคทีเรียดื้อยาสามารถหลบหนีจากบ้านของมันในลำไส้ และไปสร้างปัญหาในส่วนอื่น ๆ ของร่างกายได้ เช่น การติดเชื้อในทางเดินปัสสาวะหรือในกระแสเลือด
"ดังนั้น มันจึงเป็นที่สนใจมากว่า 'คุณจะสามารถกำจัดพวกมันออกจากลำไส้ได้หรือไม่'" ดร.เมอร์ริค เปิดเผย
แนวคิดเรื่อง "ยาอึ" ไม่ใช่เรื่องไกลตัว ก่อนหน้านี้การ "ปลูกถ่ายอุจจาระ" (faecal transplants) ได้รับการอนุมัติให้สามารถใช้รักษาอาการท้องร่วงอย่างรุนแรงที่เกิดจากแบคทีเรียคลอสตริเดียม ดิฟฟิไซล (Clostridium difficile) ได้
แต่ นักวิทยาศาสตร์ก็สังเกตว่า การปลูกถ่ายอุจจาระสำหรับรักษาอาการจากแบคทีเรียชนิดนี้นั้น ดูเหมือนว่าจะช่วยกำจัดเชื้อดื้อยาได้ด้วย
การวิจัยครั้งใหม่มุ่งเน้นไปที่ผู้ป่วยซึ่งติดเชื้อแบคทีเรียดื้อยาในช่วงเวลาหกเดือนที่ผ่านมา
พวกเขาได้รับยาซึ่งทำมาจากอุจจาระของผู้ที่บริจาคให้กับธนาคารอุจจาระ
ตัวอย่างอุจจาระแต่ละตัวอย่างถูกทดสอบให้มั่นใจว่าไม่มีการปนเปื้อนเชื้อที่ก่อให้เกิดอันตราย สกัดเอาอาหารที่ยังไม่ได้ย่อยออกไป และนำไปผ่านกระบวนการฟรีซดรายจนกลายสภาพเป็นผง
จากนั้นผงอึเหล่านี้จะถูกบรรจุลงในยาเม็ด ซึ่งสามารถผ่านท้องลงไปได้อย่างไม่บุบสลาย และจะไปละลายในลำไส้ซึ่งเป็นจุดที่เม็ดยาจะปล่อยผงอึออกมา
ที่มาของภาพ, Getty Images
แพทย์ทำการทดลองดังกล่าวกับผู้ป่วย 41 คน ที่โรงพยาบาลกายส์แอนด์เซนต์โทมัส ในกรุงลอนดอน เพื่อวางรากฐานสำหรับการศึกษาขนาดใหญ่ในอนาคต
โดยผู้ป่วยกลุ่มนี้มีความพร้อมที่จะกินยาอึ ซึ่งการทดลองพบว่าแบคทีเรียที่ได้รับบริจาคจะยังคงอยู่ในลำไส้ของผู้ป่วยอย่างน้อยหนึ่งเดือนหลังจากกินยา
ดร.เมอร์ริค กล่าวว่า นี่คือ "สัญญาณที่ดีมาก ๆ" ว่ายาอึอาจสามารถช่วยแก้ปัญหาเชื้อดื้อยาที่กำลังเป็นอันตรายมากขึ้นได้ และยังพบกว่า แบคทีเรียของผู้บริจาคสามารถช่วยทำสงครามระดับจุลินทรีย์กับเชื้อแบคทีเรียดื้อยา เพราะพวกมันจะแข่งกันแย่งอาหารรวมทั้งพื้นที่อยู่บนเยื่อบุลำไส้ และกำจัดเชื้อออกไปจนหมดสิ้นหรือ "ลดจำนวนพวกมันลงจนอยู่ในระดับที่ไม่ก่อให้เกิดปัญหา"
การศึกษายังบ่งชี้ว่า แบคทีเรียในลำไส้ของผู้ป่วยมีความหลากหลายมากขึ้นหลังการรักษา ซึ่งเป็นสัญญาณของสุขภาพที่ดี และ "อาจช่วยส่งเสริมภูมิต้านทานเชื้อต่างถิ่น" ดังนั้น แบคทีเรียที่ก่อให้เกิดอาการติดเชื้อได้จะเข้าสู่ลำไส้ได้ยากขึ้น
"มันเป็นเรื่องที่น่าตื่นเต้นมาก นี่คือการเปลี่ยนแปลงอย่างแท้จริงจากเมื่อ 20 ปีที่แล้วที่เราเชื่อว่าแบคทีเรียและไวรัสทุกตัวก่อให้เกิดอันตราย มาสู่ตอนนี้ที่เราตระหนักแล้วว่า พวกมันคือสิ่งจำเป็นมาก ๆ ต่อสุขภาพโดยรวมของเรา" ดร.เมอร์ริค ระบุ
ในช่วงสัปดาห์ที่ผ่านมานี้ นักวิทยาศาสตร์แสดงให้เห็นว่าแบคทีเรียดีที่ร่างกายของเรามักจะพบในไม่กี่ชั่วโมงภายหลังการเกิด ดูเหมือนว่าจะช่วยลดความเสี่ยงของเด็กเล็กในการเข้ารับการรักษาที่โรงพยาบาลด้วยอาการติดเชื้อในปอดลงครึ่งหนึ่ง
เซลล์มนุษย์ที่อยู่ในร่างกายของเรา มีจำนวนน้อยกว่าแบคทีเรีย เชื้อรา และเชื้ออื่น ๆ ที่อาศัยอยู่ในร่างกายซึ่งเรียกว่าไมโครไบโอม (microbiome)
ข้อมูลนี้นำไปสู่การวิจัยที่เกี่ยวข้องกับไมโครไบโอมในทุก ๆ สิ่ง นับตั้งแต่โรคโครห์น (การอักเสบเรื้อรังของเยื่อบุในระบบทางเดินอาหาร) โรคมะเร็ง ไปจนถึงสุขภาพจิต
หากยาอึได้รับการพิสูจน์ว่าได้ผลในการทำงานต่อต้านเชื้อดื้อยาในการศึกษาวิจัยขนาดใหญ่ขึ้น นักวิจัยก็คิดว่ามันอาจถูกใช้ทั้งเพื่อการรักษาและการป้องกันในผู้ที่มีความเสี่ยง
กระบวนการทางการแพทย์ที่ไปยับยั้งระบบภูมิคุ้มกัน เช่น การรักษาโรคมะเร็ง และการปลูกถ่ายอวัยวะ อาจทำให้ร่างกายอ่อนแอกว่าปกติ
"ผู้คนในกลุ่มนี้จำนวนมากได้รับอันตรายจากเชื้อดื้อยา" ดร.เมอร์ริค เปิดเผย
องค์กรควบคุมยาและผลิตภัณฑ์ดูแลสุขภาพ (Medicines and Healthcare products Regulatory Agency - MHRA) ซึ่งเป็นหน่วยงานที่กำกับดูแลเกี่ยวกับยาของสหราชอาณาจักร ระบุว่า ปัจจุบันมียาไมโครไบโอมมากกว่า 450 ชนิดที่อยู่ระหว่างการพัฒนา
"ยาบางตัวคาดว่าจะประสบความสำเร็จ ดังนั้น ฉันคิดว่า เราจะเห็นพวกมันออกมาในเวลาอีกไม่นาน" ดร.ไครซี เซอร์กากี หัวหน้าฝ่ายวิจัยไมโครไบโอม แห่ง MHRA ระบุ
"ในอนาคตนะ เราอาจจะสามารถทดแทนการใช้ยาปฏิชีวนะด้วยการใช้ไมโครไบโอม [บำบัด] ซึ่งนั่นคือภาพใหญ่ ดังนั้น มันมีแนวโน้มมากเลยแหละ"











